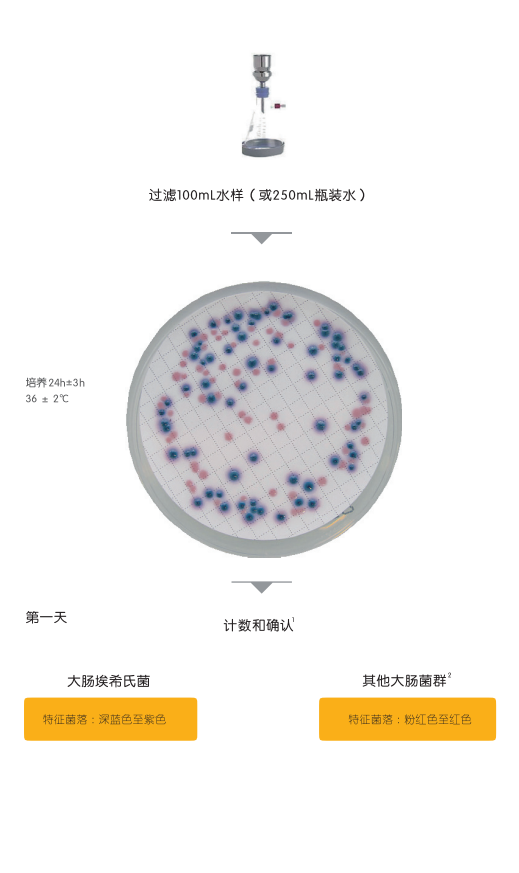

Compass CC 琼脂可在24小时内通过膜过滤法直接计数水中的大肠埃希氏菌和大肠菌群,而不需要进行典型的确认试验,如氧化酶检测或色氨酸产生吲哚。
Compass CC 琼脂适用于处理水和其他饮用水源(仅含有少量细菌)或含有高浓度干扰细菌的更高污染水源。
该方法通过 NF 认证,参考编号 BKR23/08-06/12,在24小时内对人类饮用的水中大肠杆菌和大肠埃希氏菌进行计数。
规格:
BM15308-20板
脱水基质
BK210HA-500克/瓶
选择性补充剂:
BS08408-10瓶 QSP500ml
上一条:过敏原涂抹棒
下一条:食品中大肠菌群和大肠埃希氏菌